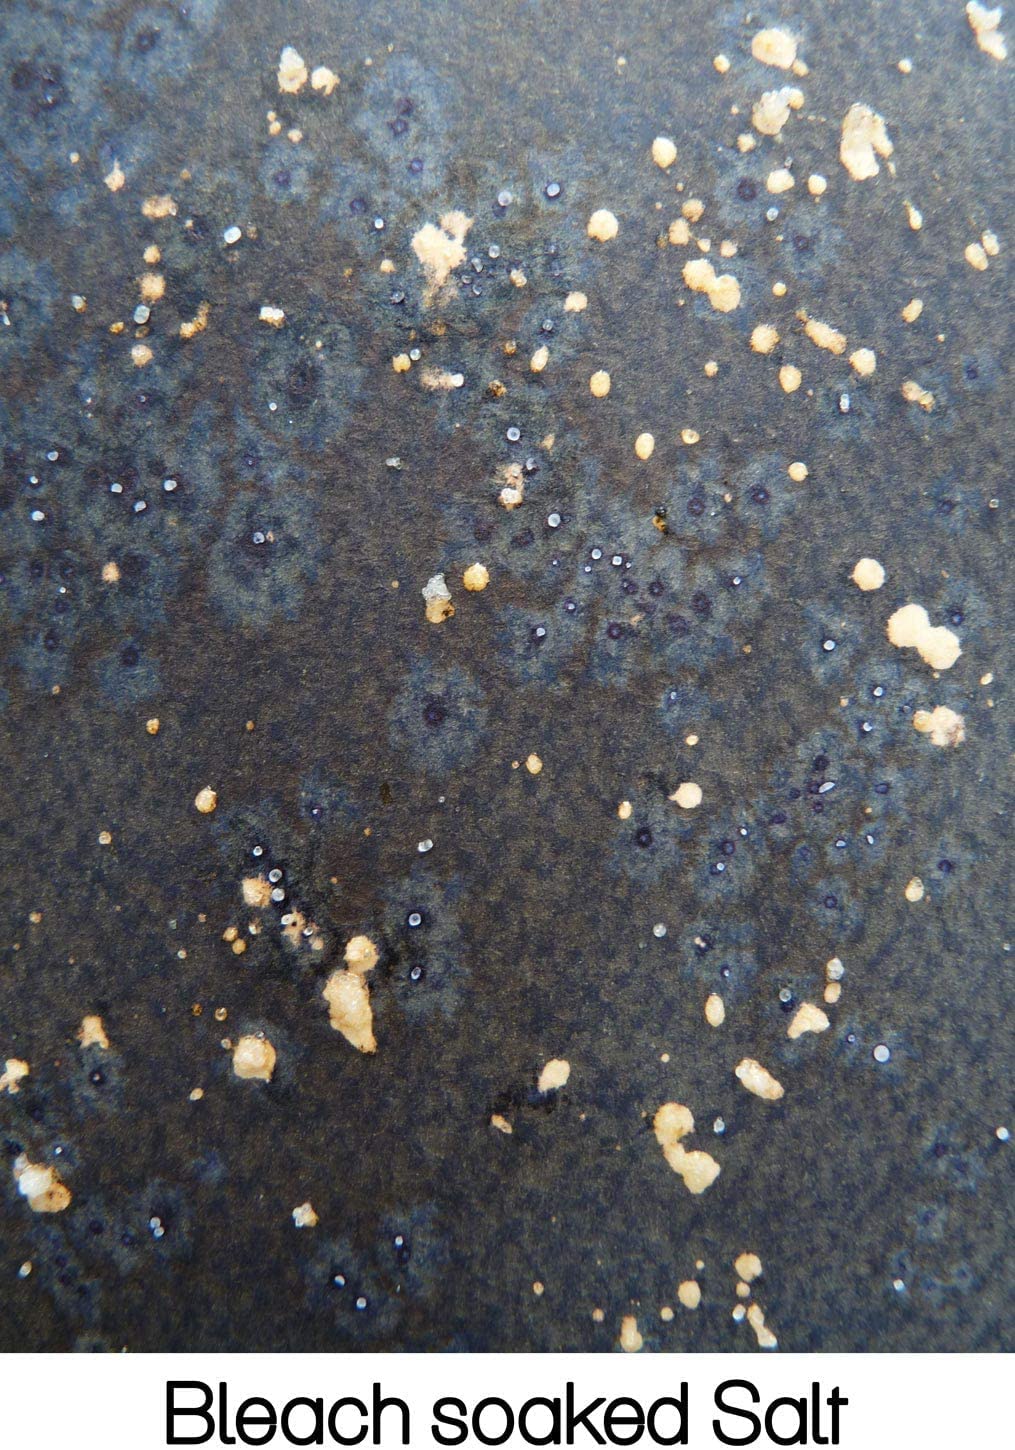
Thumbnail 2

Parker Quink Bottled Ink Permanent 57ml Bottle Blue Ref S0037470 (S0037470)
| Manufacturer | Parker |
| Brand | Parker |
| Item Weight | 5.6 ounces |
| Product Dimensions | 1.75 x 2.63 x 2.75 inches |
| Item model number | S0037470 |
| Is Discontinued By Manufacturer | No |
| Material Type | glass |
| Number of Items | 1 |
| Size | 1.9 fl oz |
| Ink Color | Blue |
| Manufacturer Part Number | S0037470 |
Trustpilot
2 months ago
3 weeks ago
1 month ago
3 weeks ago